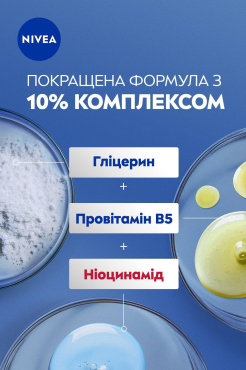
Лосьйон для тіла NIVEA Відновлення та догляд 400 мл фото 3

Лосьйон для тіла NIVEA Відновлення та догляд 400 мл
Обмін/повернення товару належної якості протягом 14 днів.
Характеристики
| Країна-виготовлення товару | Іспанія |
|---|---|
| Brand | NIVEA |
| Об'єм | 400 мл |
| Вид | Лосьйон для тіла |
| Клас косметики | Мас маркет |
| Тип | Лосьйон для тіла |
Опис Лосьйон для тіла NIVEA Відновлення та догляд 400 мл
Лосьйон для тіла NIVEA Відновлення та догляд 400 мл створений для тих, хто хоче швидко повернути шкірі відчуття комфорту, зволожити її після сухості та подразнень. Підійде для щоденного використання всім, хто цінує простоту, ефективність і надійний догляд.
Ключові переваги
- Інтенсивне зволоження до 48 годин – шкіра гладка та м’яка на дотик
- Відновлює навіть дуже суху шкіру вже після першого застосування
- Швидко вбирається, не залишає липкості
- Гіпоалергенна формула, підходить для чутливої шкіри
- Легка текстура – комфорт у використанні щодня
Вам потрібно, якщо
Вам знайома сухість, стягнутість чи дискомфорт після душу? Вам важливо, щоб шкіра не лущилась і була доглянутою без складних процедур? Це рішення для вас, якщо хочете швидко відновити м’якість і еластичність шкіри без жирних слідів та довгого чекання.
Як це працює?
Лосьйон для тіла NIVEA Відновлення та догляд містить особливий зволожуючий комплекс, який глибоко проникає в шкіру, допомагаючи відновити природний водний баланс. Засіб інтенсивно живить, зменшує лущення й подразнення, зберігає відчуття свіжості та м’якості навіть при регулярному використанні. Завдяки швидкому поглинанню, ви одразу можете одягатися після нанесення.
Спосіб застосування
Наносьте лосьйон на чисту суху шкіру легкими масажними рухами. Використовуйте щодня, особливо після душу або ванни. Для досягнення максимального ефекту приділяйте увагу найбільш сухим ділянкам тіла.
Склад
Спосіб застосування
Відгуки Лосьйон для тіла NIVEA Відновлення та догляд 400 мл
Найкращі відгуки покупців
Немає відгуків